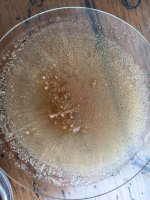
B1A59113-6B50-4AB4-96C2-F0F00BFB772F.jpeg
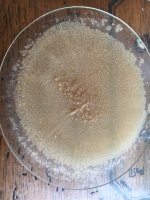
AFB2C1BA-D6B7-48EA-A34E-1324C5CA1AB4.jpeg

This is a process to extract mescaline using water, acid and ethanol. The mescaline precipitates from the ethanol in an overnight cold crash. It takes a few days, and I'm not entirely sure why it works, but it does.
Water extraction #1 - One hour boil with 12# sliced cacti, and 3 gallons of water. No vinegar used. Cacti is acidic enough on the first boil to keep the ph below 7. After the boil, strain cacti through a mesh bag. Collect filtered liquid, and set aside.
Water extraction #2 - One hour boil with fresh water and 4 oz white vinegar. Collect filtered liquid from both extractions and fridge rest overnight.
Next day - decant fridge rest liquid and reduce on the stove for a few hours. Before it gets too thick, pour through a coffee filter. Then continue reducing until you have about 12 oz. Add this reduction to a silicone tray and dehydrate overnight in a food dehydrator.
Next day, collect the resin and add it to a glass jar with 80% ethanol and 20% water. (I used 100 ml ) The resin will immediately lighten and start to break apart. Use 190 proof Everclear which is 95% alcohol. Shake jar throughout the day and poke resin with a stainless chopstick.
The next day, pour the black liquid into a new jar and add more alcohol & water (another 100 ml) The resin will transform from hard black tar into a tan jelly-like blob. This is mostly polysaccharides which you will eventually throw away. 3 alcohol pulls on the resin may be necessary to completely break down the resin.
Carefully separate the alcohol leaving the fats behind. Add the alcohol jar to the fridge for 24 hrs and you will see mescaline crystals crash out at cold temps. Pour the contents of the jar through a coffee filter, the mescaline crystals will remain in the coffee filter. (first picture below)
Once crystals are dry, I wash with Ethyl Acetate which removes the stickiness and lightens the color. (picture 2)
1.5 grams from 12 pounds of Pachanoi
Water extraction #1 - One hour boil with 12# sliced cacti, and 3 gallons of water. No vinegar used. Cacti is acidic enough on the first boil to keep the ph below 7. After the boil, strain cacti through a mesh bag. Collect filtered liquid, and set aside.
Water extraction #2 - One hour boil with fresh water and 4 oz white vinegar. Collect filtered liquid from both extractions and fridge rest overnight.
Next day - decant fridge rest liquid and reduce on the stove for a few hours. Before it gets too thick, pour through a coffee filter. Then continue reducing until you have about 12 oz. Add this reduction to a silicone tray and dehydrate overnight in a food dehydrator.
Next day, collect the resin and add it to a glass jar with 80% ethanol and 20% water. (I used 100 ml ) The resin will immediately lighten and start to break apart. Use 190 proof Everclear which is 95% alcohol. Shake jar throughout the day and poke resin with a stainless chopstick.
The next day, pour the black liquid into a new jar and add more alcohol & water (another 100 ml) The resin will transform from hard black tar into a tan jelly-like blob. This is mostly polysaccharides which you will eventually throw away. 3 alcohol pulls on the resin may be necessary to completely break down the resin.
Carefully separate the alcohol leaving the fats behind. Add the alcohol jar to the fridge for 24 hrs and you will see mescaline crystals crash out at cold temps. Pour the contents of the jar through a coffee filter, the mescaline crystals will remain in the coffee filter. (first picture below)
Once crystals are dry, I wash with Ethyl Acetate which removes the stickiness and lightens the color. (picture 2)
1.5 grams from 12 pounds of Pachanoi
Attachments
Last edited:







 the crystals are more dense than I expected just looking at the beaker.
the crystals are more dense than I expected just looking at the beaker.